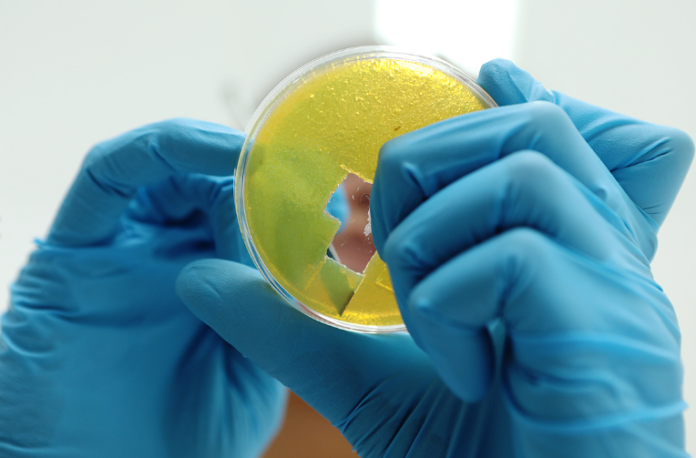

A través de una técnica denominada espectroscopia microRaman se puede determinar el tipo de plaguicida presente y estimar en qué cantidad.
A través de una técnica denominada espectroscopia microRaman se puede determinar el tipo de plaguicida presente y estimar en qué cantidad.
Un grupo de investigadoras de la UNLP desarrolló un gel de agar con nanopartículas de plata (sustratos SERS) que permite detectar la presencia de plaguicidas sobre las cáscaras de diferentes frutas y vegetales, aun en pequeñas concentraciones.
Si bien estas sustancias, en muchos casos, pueden penetrar las cáscaras, es esperable que la mayor concentración de los residuos se encuentre sobre ellas. Además, muchas frutas y vegetales son ingeridas con cáscara, ya que las mismas aportan fibras y otros componentes muy beneficiosos para la salud.
Este trabajo fue financiado por la Agencia Nacional de Promoción de la Investigación, el Desarrollo Tecnológico y la Innovación, el CONICET y la UNLP. La metodología fue desarrollada por científicas del CEQUINOR (Centro de Química Inorgánica) perteneciente a la Facultad de Ciencias Exactas de la Universidad Nacional de La Plata, al CONICET y asociado a la CIC – PBA.
Una de las autoras del trabajo, la doctora Rosana Romano, explicó de qué se trata este desarrollo. “El método aplicado consiste en extraer, a partir del contacto de las cáscaras con el gel de agar con nanopartículas de plata pequeñas cantidades de plaguicidas. Luego, esos geles se llevan al laboratorio y, a través de la utilización de una técnica denominada ‘espectroscopia microRaman’, podemos determinar el tipo de plaguicida presente y estimar además en qué cantidad. En este proceso se utiliza una pequeña dosis de solvente con el objetivo de disolver los residuos de plaguicidas presentes en la cáscara y favorecer así su traspaso al gel para su posterior determinación”.
Los ensayos
El método se ensayó en varias frutas y vegetales, entre ellos, manzana, tomate, berenjena, frutilla, morrón y cereza.
Una vez que se extrae el plaguicida por contacto entre el gel y la superficie de las cáscaras, el material es colocado sobre un portaobjeto para luego ser llevado al laboratorio. “El método es muy sencillo y una vez realizada la extracción sobre las superficies de las cáscaras, los geles se colocan sobre portaobjetos. Luego, para poder analizarlos es necesario esperar a que los mismos pierdan la humedad. Este proceso de deshidratación no lleva más de 24 horas. Una vez transcurrido ese tiempo se realizan las medidas que permiten detectar la presencia o no de estas sustancias en cáscaras de diversas frutas y vegetales”, agregó la Doctora María Luz Rizzato, quien recientemente presentó su Tesis Doctoral sobre esta temática.
Cabe destacar que las señales provenientes de los plaguicidas ensayados fueron observadas aun después de un año de realizarse las primeras medidas. Es decir, el gel conserva tanto a los plaguicidas como a las nanopartículas de plata que siguen exhibiendo señales, incluso con el paso del tiempo.
Las ventajas de este método radican principalmente en que es no invasivo y puede ser utilizado in situ, ya que pueden tomarse las muestras en donde se requiera para luego llevar el gel al laboratorio y realizar las determinaciones. La versatilidad de este gel fue demostrada también al ser empleado para la detección de cocaína en billetes de curso legal. Además, se prevé su utilización para detectar otras sustancias de interés sobre distintas superficies, entre ellos la determinación de pigmentos en obras de arte”, concluyeron las investigadoras. (DIB) ACR




